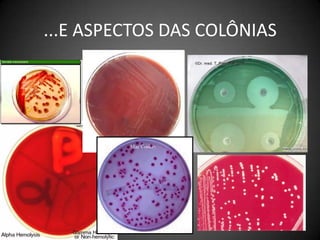
...E ASPECTOS DAS COLÔNIAS
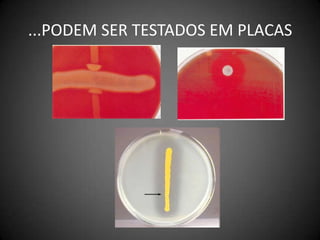
...PODEM SER TESTADOS EM PLACAS
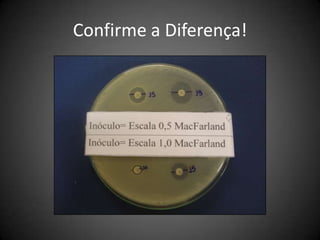
Teste de sensibilidade aos antimicrobianosBactéria e Preparo do Inóculo Suspensão direta
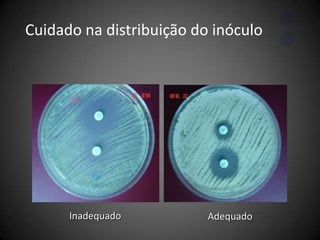
Método de crescimento0,5 McFarland 1a 2x108 UFC/mL

O documento discute os mecanismos da patogenicidade bacteriana, incluindo como bactérias invadem o corpo humano, colonizam tecidos e causam doenças. Detalha fatores como adesão, toxinas, biofilmes e resistência aos antibióticos que permitem a sobrevivência e disseminação de bactérias patogênicas.